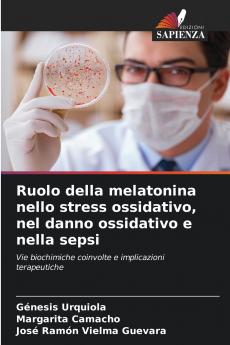
Ruolo della melatonina nello stress ossidativo nel danno ossidativo e nella sepsi

Paperback
₹5186
₹6831
24.08% OFF
(All inclusive*)
Delivery Options
Please enter pincode to check delivery time.
*COD & Shipping Charges may apply on certain items.
Review final details at checkout.
Looking to place a bulk order? SUBMIT DETAILS
About The Book
Description
Author(s)
Per descrivere i concetti generali di radicali liberi stress ossidativo danno ossidativo e le evidenze ottenute in modelli in vivo e in vitro sul potenziale uso della melatonina in diverse infezioni batteriche (Gram-positive e Gram-negative) e nello sviluppo della sepsi abbiamo condotto una revisione sistematica qualitativa con criteri di validazione delle informazioni utilizzando sette motori di ricerca meta-motore di ricerca e database: Google Scholar WebMD Trip Medscape PubMed NICE e Scielo che hanno permesso di recuperare 380 documenti.792 documenti utilizzando una combinazione di parole chiave in inglese e spagnolo e l'uso di operatori booleani: AND OR o NOT. La complessa fisiopatologia delle diverse infezioni batteriche e della sepsi ci ha permesso di dedurre che esiste un cross-talk tra stress ossidativo danno ossidativo attività antiossidante immunità innata e mitocondri. L'analisi delle prove ci ha permesso di evidenziare che la melatonina agisce come antinfiammatorio attraverso le vie del Fattore Nucleare Kappa Beta e dell'inflammasoma NLRP3; oltre alle sue proprietà di scavenger dei radicali liberi.
Delivery Options
Please enter pincode to check delivery time.
*COD & Shipping Charges may apply on certain items.
Review final details at checkout.
Details
ISBN 13
9786208687663
Publication Date
-27-02-2025
Pages
-68
Weight
-106 grams
Dimensions
-152x229x4.14 mm